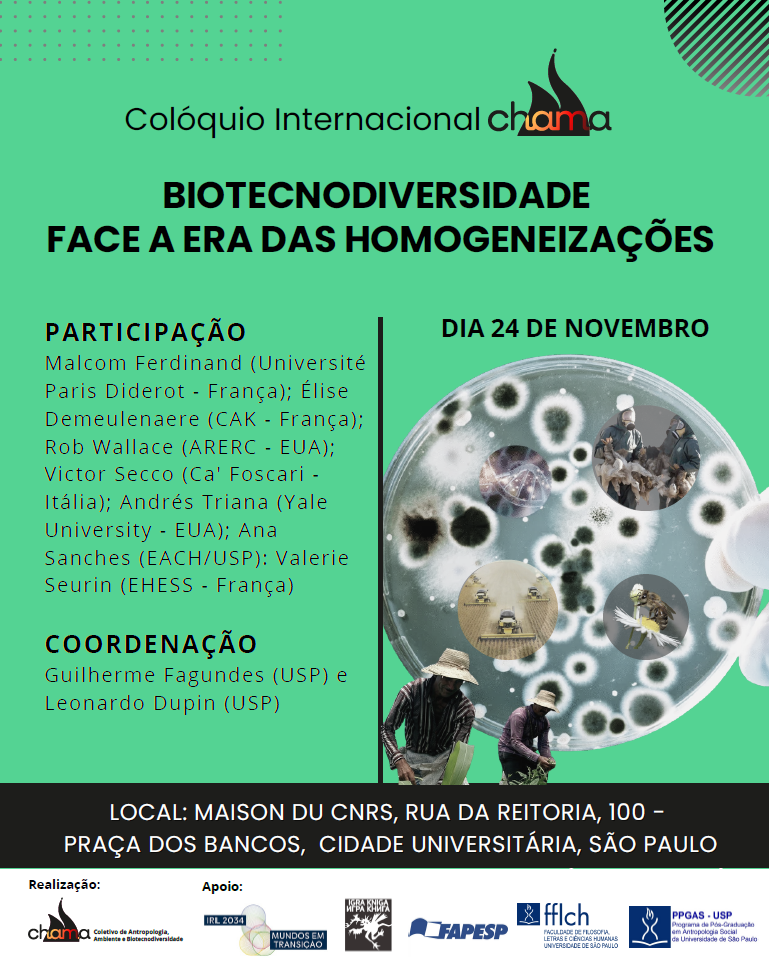

2025
4 décembre

Séminaire : Contas do capitalismp: uma sociologia dos seus novos operadores
Organisé par: Fabrice Bardet, Ruy Braga, Lena Lavinas, Cibele Rizek et Fábio Zuker
Evénement en partenariat entre : CENEDIC FFLCH/USP – IBICT, IRC CNRS/USP « Transitions », IRL2034 Mondes en transition
Date et horaire : 4 décembre 2025, de 10h à 16h
Lieu : Maison du CNRS, Rua da Reitoria, 100 Cidade universitária de Butantã
2 décembre

Séminaire : Big Data e Transição Ecológica: Quem Conta?
Organisé par: Fabrice Bardet, Ruy Braga, Lena Lavinas, Cibele Rizek et Fábio Zuker
Evénement en partenariat entre : CENEDIC FFLCH/USP – IBICT, IRC CNRS/USP « Transitions », IRL2034 Mondes en transition
Date et horaire : 2 décembre 2025, à partir de 9h30
Lieu : Auditório da Casa de Cultura Japonesa – USP
28 novembre

Conférence : Soft power et circulations culturelles transatlantiques : le tournant des années 1960-1980
par : Robert Frank, professeur de relations internationales Université Paris 1 Panthéon-Sorbonne
Présentation : Gabriela Pellegrino Soares professeure au département d’histoire de l’Université de São Paulo
Médiation : Alexandre Moreli, professeur de l’Instituto de Relações Internacionais de l’Université de São Paulo
Evénement en partenariat entre : Departamento de Historia / FFLCH-USP, Instituto de Relações Internacionais / USP, Escola Interdisciplinar de Humanidades / FAPESP, IRP Transatlantic Cultures / CNRS, Consulat général de France à São Paulo, IRL2034 Mondes en transition
28 novembre 2025, de 16 à 19h à la Maison du CNRS
24 novembre
Colloque international Chama: BIOTECNODIVERSIDADE FACE A ERA DAS HOMOGENEIZAÇÕES
organisé par : Guilherme Moura (USP) et Leonardo Dupin (USP)
Avec : Malcom Ferdinand (Université Paris Diderot); Élise
Demeulenaere (Centre Alexandre Koiré); Rob Wallace (ARERC);
Victor Secco (Ca’ Foscari); Andrés Triana (Yale
University); Ana Sanches (EACH/USP): Valerie Seurin (EHESS)
Evénement en partenariat entre le Coletivo de Antropologia, Ambiente e Biotecnodiversidade (CHAMA/USP) et l’IRL2034 Mondes en transition
24 novembre 2025 à la Maison du CNRS
13 novembre

Ciclo de Conferências « Fazer sociedade. Tecendo laços em um mondo em transição »
Sessão 3: Fazer sociedade diante das catástrofes ambientais
Evénement en partenariat entre le Département de sociologie de la FFLCH-USP et l’IRL2034 Mondes en transition
13 novembre 2025, de 14h à 17h à la Maison du CNRS
Présentations de Ricardo Abramovay (USP), Arislon Favareto (USP Cátedra Josué de Castro et CCI/CRBAP), commentaires de Serge Paugam (IRL2034 CNRS/USP), séminaire coordonné par François-Michel Le Tourneau (IRL2034 CNRS/USP)
11 novembre

Conférence : Existe-t-il des philosophies africaines ? Ethnophilosophie, géophilosophie, philosophie comparée et pensée en Afrique
par : Frédéric Fruteau de laclos, professeur de philosophie de l’environnement et phislosophie des sciences humaines (Université Paris-Est Créteil)
Evénement en partenariat entre le consulat général de France à São Paulo et l’IRL2034 Mondes en transition
11 novembre 2025, de 17h à 19h à la Maison du CNRS
6-7 novembre

Rencontre Plénière IRP ALCOM Contributions de l’Amérique latine à l’esquisse d’un droit commun
Un événement organisé par l’Institut des Sciences juridiques et philosophiques de l’Université Paris 1 Panthéon Sorbonne, la Faculté de Droit de l’Université de São Paulo et entre l’IRL2034 Mondes en Transition.
Programme et liens de visioconférence sur https://isjps.pantheonsorbonne.fr/evenements/irp-alcom-rencontre-pleniere.-contributions-lamerique-latine-lesquisse-dun-droit-commun
Date et lieu : le 6 novembre 2025 14h30-18h30 et 7 novembre 2025 9h-18h à la Maison du CNRS (Rua da Reitoria, 100 – Cité Universitaire de Butantã)
6 novembre

Désencapsuler le droit du climat : 10 ans de l’accord de Paris
Workshop international organisé par Aix-Marseille Université (Faculté de droit et de science politique, UMR DICE) et l’Université de Rennes (Faculté de droit, UMR IODE) en association avec l’Université de Brasilia (dans le cadre de l’École d’été de droit de l’environnement : Climat, eau et océans) et l’International Research Laboratory (IRL) Mondes en Transition du CNRS.
Evénement en deux parties, 4/11/2025 à l’Université de Brasilia et 6/11/2025 au Laboratoire Mondes en Transition. Programme sur https://desencapsuler.sciencesconf.org/
Date et lieu : le 6 novembre 2025 9h-13h à la Maison du CNRS (Rua da Reitoria, 100 – Cité Universitaire de Butantã)
30 octobre

Conversation sur la COP30 autour du projet CLIMACOP 2
Porté par le CREDA, le CNRS, l’IRD, l’Université de Hambourg et le Climate Social Science Network (Brown University), le projet international « ClimaCOP 2, une ethnographie collaborative de la COP 30 sur le climat » vise à documenter, depuis l’Amazonie, les tensions d’une politique climatique mondiale en crise. L’équipe du CREDA fera partie de la délégation française à la COP 30.
En amont de la COP, Léa Lebeaupin-Salamon (CREDA) et Livia Kalil (CREDA) participeront à une rencontre organisée à la Maison du CNRS de São Paulo (Université de São Paulo – IRL Mondes en Transition; Rua da Reitoria, 100 – Cité Universitaire de Butantã) le 30 octobre à 14h, pour présenter le projet ClimaCOP 2 et le programme « Cartographier les compromis climatiques dans les Amériques ».
🔗 En savoir plus : https://climacop.hypotheses.org/le-projet-climacop et https://cssn.org/
Photo : Midia NINJA (CC BY 4.0)
29-31 octobre

Viajantes franceses no Brasil: releituras crÍticas
Colloque et exposition organisés par Michel Riaudel, Fernanda Pitta et Tiganá Santana, avec le soutien de la Biblioteca Brasiliana Guita e José Mindlin (BB%-USP), l’Institut d’Etudes Brésiliennes, (IEB-USP), le musée d’Art contemporain (MAC-USP), le centre Mariantônia (USP), Sorbonne Université et l’IRL2034 Mondes en transition
Programme, lieux et infomations : https://viajantesfrancesesleiturascriticas.com
29 octobre

La Francophonie et la circulation internationales des savoirs : Brésil, France, Canada e Belgique
Un événement en partenariat entre l’IRL2034 Mondes en Transition, l’Institut d’études avancées de l’Université de São Paulo et le réseau BRACEF.
Présentations :
- – Serge Jaumain (Université Libre de Bruxelles) Le projet canadien « Trois siècles de migrations francophones en Amérique du Nord » : perspectives de développement vers le Brésil
- – Raimundo Nonato Jr. (Universidade Federal do Rio Grande do Norte) Le reseau Bracef et la recherche en coopération franco-belge-brésilienne
- – Marisa Midori Deaecto (Universidade de São Paulo) Histoire du livre, Histoire de l’édition et la question de la francophonie en échelle internationale
Date et lieu : le 29 octobre 2025 à partir de 14h à la Maison du CNRS (Rua da Reitoria, 100 – Cité Universitaire de Butantã)
24 octobre

Comment le Brésil et l’Europe peuvet-ils être les leaders de l’action climatique ?
Un dialogue pré-COP entre Carlos Nobre et François Gemenne, organisé en partenariat par le Consulat général de France à São Paulo, le SESC et l’IRL2034 Mondes en Transition.
Le 24 octobre 2025 à partir de 16h, au SESC / Centro de Pesquisa e formação, Rua Dr. Plinio Barreto, 285, 4to andar, Bela Vista São Paulo
22 octobre

A terra e a pena (1996) e Amazônia, luz e sombras (2021)
Deux films de Frédéric Létang
Session de cinéma spéciale en partenariat avec CINUSP et le LISA. Les deux documentaires font le portrait du même groupe de colons amazoniens, une première fois en 1996 et une seconde fois en 2021, montrant tout le parcours de la région du sud-est du Pará dans cet intervalle.
La séance commencera à 14h pour le premier documentaire, et les deux seront montrés en séquence.
Le débat après la projection aura lieu en présence du réalisateur, Frédéric Letang; de João Godoy, professeur du Département de Cinéma, Télévision et Radio de l’école de Communication et des Arts (ECA) de l’ Université de São Paulo, qui a collaboré, comme ingénieur du son au premier film de Frédéric Letang et avec Henri Gervaiseau, vice-directeur du CINUSP, cinéaste et professeur du Département de Cinéma, Télévision et Radio de l’école de Communication et des Arts (ECA) de l’ Université de São Paulo.
9 octobre

Ciclo de Conferências « Fazer sociedade. Tecendo laços em um mondo em transição »
Sessão 2: Fazer sociedade para além do assalariamento
Evénement en partenariat entre le Département de sociologie de la FFLCH-USP et l’IRL2034 Mondes en transition
09 octobre 2025, de 14h à 17h à la Maison du CNRS
Présentations de Adalberto Cardoso (IESP-UERJ) et Leonardo Fontes (Unicamp), commentaires de Serge Paugam (IRL2034 CNRS/USP)
7-8 octobre

As palavras e as coisas, 60 anos do curso de Michel Foucault na Universidade de São Paulo
Partie I : le cours 7 octobre 2025 – 14h30 Marilena Chaui (USP) Pedro Paulo Pimenta (USP) Alessandro Francisco (IA-Unesp et CIPh) Philippe Sabot (Université de Lille et Centre Michel Foucault)
Partie II : développements 8 octobre 2025 – 14h30 Alex de Campos Moura (USP) Orazio Irrera (Université Paris 8) Salma Tannus Muchail (PUC-SP) Claude Imbert (École normale supérieure de Paris)
Organisation Alex de Campos Moura (USP) Alessandro de Lima Francisco (UNESP ; CIPh, Paris)
Partenariat: PPG-Fil/FFLCH-USP, CAPES/PROEX, IA-UNESP, Centre Michel Foucault, CIPh, CNRS, IRL 2034 Monde en Transition, Université de Lille, Consulat général de France à São Paulo
Lieu Maison du CNRS – USP Adresse Rua da Reitoria, 100, Cidade Universitária, São Paulo – SP
29 septembre

Explorando a vida cotidiana de um bairro popular: objetivação, teorias e métodos
Oficina 1: explorando a vida econômica de um bairro popular
Séance avec André Nahoum (USP) et Maria Liliana Barriga (PROAM-USP)
Salle 112 (LAPS), prédio da Filosofia e Ciências Sociais da FFLCH-USP, de 14 à 16h
Organisation Laboratório de Pesquisa Social (LAPS)/IRL2034 Mondes en transition
25-26 septembre

Cours Cadeias operatórias, tornando visíveis os processos técnicos
25 et 26 septembre 2025 à la Maison du CNRS,
Cours donné par Ludovic Coupaye, diretceur du Centre for the Anthropology of Technics and Technodiversity (CATT) – University College London
en partenariat avec les groupes de recherche CHAMA (coletivo de Antropologia, Ambiente e Biotecnodiversidade) et METIS (Artes semântica da criação e da memória), avec le soutien du LISA (laboratório de Imagem e Som de antropologia), PPGAS-USP , CATT-UCL
25 septembre

Séminaire : « Gestion environnementale dans un monde en transition »
25 septembre 2025, de 9h à 17h à l’auditorium rouge de l’Escola de Artes, Ciência e Humanidades (EACH-USP)
Séminaire en partenariat entre le cours de gestion environnementale de l’EACH-USP et l’IRL2034 Mondes en transition
Programme détaillé sur https://www.semanasfrancouspianas.com/session/s40
17-19 septembre

Colóquio Internacional « Mundos em transição: novas abordagens do trabalho de campo »
du 17 au 19 septembre 2025 à la Maison du CNRS et à l’auditorium du Laboratoire d’image et de son en anthropologie (LISA) de l’USP
Programme complet: https://www.semanasfrancouspianas.com/event/e7
Inscriptions : https://www.even3.com.br/mundos-em-transicao-novas-abordagens-do-trabalho-de-campo-616676
11 septembre

Ciclo de Conferências « Fazer sociedade. Tecendo laços em um mondo em transição »
Sessão 1: Para Além da Família
Evénement en partenariat entre le Département de sociologie de la FFLCH-USP et l’IRL2034 Mondes en transition
11 septembre 2025, de 14h à 17h à la Maison du CNRS
Présentations de Cynthia Sarti (UNIFESP) et Nadya Auraujo Guimarães (DS/USP), commentaires de Eugênia Motta (UFRJ et USP)
15 août

Antropologia da Astrobiologia – Palesta de Perig Pitrou (collège de France)
L’évenément aura lieu en français avec traduction simultanée.
Evénement en partenarait entre le collectif Anthropologie, Environnement et Biotechnodiversité (CHAMA/USP) et l’IRL2034 Mondes en transition (CNRS/USP), avec l’appui de la Fondation José Luiz Setúbal et de la CAPES.
La venue de Perig Pitrou au Brésil se réalise dans le cade de la II Winter School FFLCH/USP 2025, organisée par la comission de l’internationalisation de l’USP et par la PRCEU/USP.
Lieu : Maison du CNRS
Date et horaire : vendredi 15 août de 14:30 à 16h30.
11-14 août

Ciclo de Aulas: Migrações, Línguas e Hospitalidade – Perspectivas criticas multidisciplinares par Marie-Caroline Saglio-Yatzimirsky
Événement organisé par Ana Carolina Maciel, en partenariat entre l’Universidade Estadual de Campinas (UNICAMP), l’institut Convergences Migration (ICM) et l’IRL 2034 Mondes en transition (CNRS-USP). En portugais.
Durée: 4 cours de 2h30
Objetivo geral: Compreender as interações entre migração, linguagem, exclusão e hospitalidade a partir de uma perspectiva antropológica, linguística, psicológica e política
11/08 14h30 : Aula 1 – Migrações e Línguas: Violência e resistencia
12/08 14h30 : Aula 2 – O Relato dos Exilados: Trauma e Temporalidade
13/08 14h30 : Aula 3 – Mediações Linguísticas e Culturais: A Hospibabelidade
14/08 : 14h30 : Aula 4 – Descentrar as Línguas e os Conceitos: Novos Caminhos Teóricos em Migração
Lieu : Maison du CNRS, campus Butantã
6 août

A estruturação das desigualdades de emprego pelas plataformas de serviços domésticos: um enquadramento analítico
Palestra da Professora Dr. Léa Lima (LISE – CNAM)
Événement organisé par Nadya Araujo (département de sociologie de l’Université de São Paulo et Centre d’Observation des Institutions brésiliennes – COI); le Laboratoire Interdisciplinaire pour la Sociologie Economique (LISE) du Conservatoire National des Arts et Métiers (CNAM) et l’IRL 2034 Mondes en transition (CNRS-USP). En portugais.
Horaire: 10-12h le 6/08/2025
Lieu : Maison du CNRS, campus Butantã
1-2 juillet

Cycle de conférences avec Anne-Charlotte Martineau (Centre de Théorie et Analyse du Droit, Université de Paris Nanterre, professeure à l’École Normale Supérieure)
Événement organisé par Claudia Perrone-Moisés, en partenariat entre l’IRL 2034 Mondes en transition et faculté de droit de l’Université de São Paulo.
1er juillet 9h : O direito internacional no centro do Antropoceno: uma história das relações entre o direito internacional e a destruição do meio ambiente (en anglais)
Debateurs :
– Camila Perruso (Université de Montpellier Paul-Valéry)
– Hugues Hellio (Université d’Artois)
2 juillet 10h : Gaza e o Retorno da « Guerra Justa » nas Relações Internacionais: algumas reflexões teóricas e históricas (en français)
Debateurs : Carlos Zeron (Departamento de História – FFLCH|USP)
Lieu : Auditório Ruy Barbosa Nogueira, 2o andar do Prédio, Histórico da FDUSP
23-24 juin

Colloque international en hommage à Afrânio Garcia
Événement en partenariat entre l’EDUSP, la Reitoria de l’Université de São Paulo, le département de sociologie, la FFLCH, l’IRL 2034 Mondes en transition et le Consulat général de France à São Paulo.
Ouverture Sergio Miceli (EDUSP), Maria Arminda do Nascimento Arruda (vice-rectrice USP), Marie-France Garcia (EHESS) et François-Michel Le Tourneau (IRL2034 Mondes en transition)
Lieu : Maison du CNRS
6 juin

Lancement du livre de S. Paugam A sociedade em laços
Événement organisé en partenariat entre l’IRL 2034 Mondes en transition et le département de sociologie de l’Université de São Paulo.
Conversation avec Serge Paugam (CNRS), Nadya Araujo-Guimarães (DS-USP), Lena Lavinas (UFRJ), André Magnelli (diretor do Ateliê de humanidades), Daniel Guimarães (PPGS-USP)
Lieu et date: Sala Alfredo Bosi, Rua Praça do Relogio, 109, sala 17 Térreo – Cidade Universitaria
30 mai

Nutrição e alimentação, desafios do século XXI
Événement organisé en partenariat entre le Consulat général de France à São Paulo, l’IRL 2034 Mondes en transition et l’INCT Combate à Fome de l’Université de São Paulo.
Présentations :
- Brieux Pont (Secrétaire général du sommet N4G Nutrition for Growth) : « A nutrição, uma ferramenta indispensável para a emancipação dos povos »
- Marcelo Cândido da Silva (INCT Combate à Fome – USP) : « Brasil e os ‘custos ocultos’ da produção de alimentos »
- Lilian dos Santos Rahal (Ministério do Desenvolvimento e Assistência social, Família e Combate à Fome) : « Programas de Segurança Alimentar e Nutricional para todas as formas de má nutrição »
Lieu et date: Maison du CNRS, 30/05/2025 à partir de 10h
9 mai

Amatiwana Trumai. A pintura da nostalgia
Événement organisé par le CEstA/USP en partenariat avec l’IRL 2034 Mondes en transition.
Projection de film et conversation avec Emmanuel de Vienne (Université Paris Ouest Nanterre et IRL2034 Mondes en transition)
6 mai

Transparência democrática: o lado obscuro da Open Source INTelligence
Événement de l’IRL 2034 Mondes en transition et du LABGOV FD-USP, en partenariat l’université Bordeaux Montaigne et le centre Understanding Artificial Intelligence (UAI-USP).
Présentation et conversation avec Allan Deneuville, enseignant-chercheur de l’université Bordeaux Montaigne, co-fondateur du groupe de recherche et création « Après les réseaux sociaux » (http://after-social-networks.com), chef du département recherche de l’association de recherche sur les sources libres Open Facto (https://openfacto.fr), Vice-président des relations internationales de la SFSIC (Société Française de sciences de l’information et de la communication).
Médiation : professeure Catarina Ianni Segatto (DCP/USP)
22 Avril

Transformação e revitalização de línguas indígenas
Événement de l’IRL 2034 Mondes en transition et du Museu de Arqueologia e Etnologia (MAE), en partenariat avec le consulat de France à São Paulo, le centre EREA du LESC (UMR 7186) et l’EUR EDGES.
Organisateurs : Maria-Luisa Lucas et Emmanuel de Vienne
16h Pedro de Niemeyer Cesarino (Departamento de antropologia/USP) Línguas indígenas: tradições eruditas e tradução
16h30 Maria Luisa Lucas (MAE) Tabaco, celulares, cartões de memória e outras ferramentas indígenas de gestão de dados para recuperar e transformar repertórios rituais na Amazônia.
17h Aria Trumai, Tsinakoro Trumai e Emmanuel de Vienne (IRL-Paris Nanterre) Como resgatar a língua Trumai ? O exemplo da aldeia Wani Wani (TI Capoto-Jarina)
17h30 Antonio Guerreiro Júnior, (Departamento de Antropologia/Unicamp), Marina Pereira Novo (Departamento de Antropologia/Unicamp), Veronica Monachini (PPGAS/Unicamp), Ugise Kalapalo, (PPGAS/Unicamp) Oralidade, escrita e educação escolar indígena: reflexões a partir do contexto Kalapalo (Alto Xingu, MT).
18h Luciana Storto Comentários
18h30 Discussão
7 Avril
Franceses no Brasil, séculos XIX-XX
Organisé en partenariat entre l’IRL 2034 Mondes en transition, l’école de communication et arts (ECA) de l’Université de São Paulo, l’Universidade Estadual Paulista et le consulat général de France à São Paulo.
avec
Laurent Vidal (Université de La Rochelle)
Tania de Luca (UNESP – Assis)
Marisa Midori (ECA-USP)
Isabel Chrysostomo (UFV – UFRJ)
25 Mars
O que pode a cultura contra o racismo?
Organisé en partenariat entre l’IRL 2034 Mondes en transition, le département de sociologie de l’Université de São Paulo et le consulat général de France à São Paulo.
avec
Michel Agier (EHESS/IRD)
Ouverture:
Serge Paugam (CNRS/EHESS; professor visitante do departamento de sociologia, FFCH/USP; pesquisador participante IRL2034 Mondes en transition CNRS/USP)
Débateurs :
Ângela Alonso (Departamento de sociologia, FFCH/USP)
Antônio Sergio Guimarães (Departamento de sociologia, FFCH/USP)
13 Mars

Museus em processo: um diálogo entre o Brasil e o Benin
Organisé en partenariat entre l’IRL 2034 Mondes en transition et le musée d’archéologie et d’ethnologie de l’USP
com Arnaud Zohou (Museu do Vodun, Benin) e Hélio Menezes (Museu Afro Brasil)
Organização / mediação:
Stefania Capone (IRL2034 Mundos em transição CNRS/USP)
Rosa Cavalcanti Ribas Vieira (MAE /USP)
12 février
Archéologie, écologie historique, géographie et environnement : approches croisées de l’Amazonie brésilienne et de la Guyane française
Organisé en partenariat entre l’IRL 2034 Mondes en transition, le musée d’archéologie et d’ethnologie de l’USP et le consulat général de France à São Paulo.
Interventions :
- Guillaume Odonne : interactions entre humains et plantes, des dynamiques à long terme aux dynamiques contemporaines, perceptions de la région du Bouclier guyanais (et ses environs).
- Julien Cambou : Gestion partagée du patrimoine naturel et culturel du sud de la Guyane française.
- François-Michel Le Tourneau : histoire et géographie de la frontière terrestre entre le Brésil et la France.
- Eduardo Góes Neves : le Projet Amazonie Révélée. Archéologie et protection des zones menacées en Amazonie.
